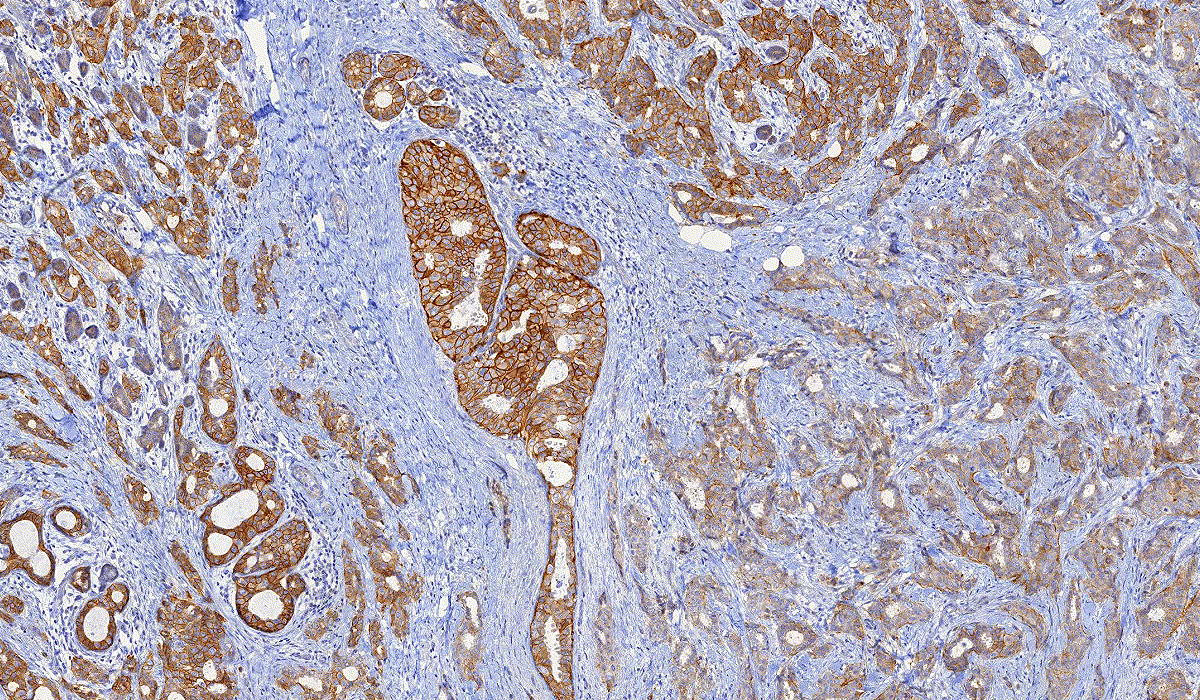

DensitoQuant is an easy-to-use, fast and accurate, stain-intensity-based IHC quantification tool.
DensitoQuant
DensitoQuant
DensitoQuant is an easy-to-use, fast and accurate, stain-intensity-based IHC quantification tool.
DensitoQuant Module in QuantCenter
A special IHC color calibration option is integrated into these quantification modules, facilitating software integration to the local laboratory. By applying this function the software can be calibrated to the sample quality (local laboratory stain protocol, or different stainer), resulting in an adequate measurement.
DensitoQuant is an easy-to-use, fast and accurate, stain-intensity-based IHC quantification tool. The application identifies the positive stain, based on an automatic color separation method through which individual positive pixels are counted and classified based on intensity and threshold ranges. This way, an H-Score can be calculated based on the proportion of positive and negative pixels.